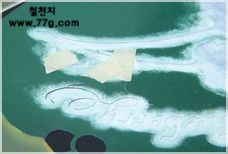

DIY 기술지원

가구의 포인트 아크릴칼라 사용법 2 가구의 포인트를..(스탠실 기법)(동영상)
2006-01-11|조회수: 13734|작성: 77g
이런 재료를 준비하세요
관련 기술지원
 (접이식 식탁 겸 콘솔)테이블 - 업그레이드 디자인으로 멋지게 연출하기
(접이식 식탁 겸 콘솔)테이블 - 업그레이드 디자인으로 멋지게 연출하기2007-06-28

 가구의 포인트 아크릴칼라 사용법 1 (크랙킹 기법)(동영상)
가구의 포인트 아크릴칼라 사용법 1 (크랙킹 기법)(동영상)2006-01-11
관련 상품
단순한 화병이나,보석함,잡지꽂이 등등 아크릴칼라로 화려하고 예쁘게 변신할 수 있습니다.
전체를 아크를 물감으로 칠할수도 있지만, 바탕을 다른 페인트로 칠하고. 그림만 스탠실 효과를 이용하여 아크릴 물감으로 포인트를 줄수 있습니다.
스텐실 효과는 기존에 나와 있는 도안을 이용하는 방법도 있지만, 트레팔 지를 이용하여 직접 도안을 오려서 만들어 사용할수도 있습니다.
전문가만이,아니면 꼭 배우는곳에서 지도를 받아야 할수 있다고 생각하시는게 대부분인데요,
나뭇잎이나,꽃 정도는 방법만,순서만 안다면 초보자도 처음하는 분들이라도
금방 따라하실수 있습니다.
스텐실 효과는 기존에 나와 있는 도안을 이용하는 방법도 있지만, 트레팔 지를 이용하여 직접 도안을 오려서 만들어 사용할수도 있습니다.
전문가만이,아니면 꼭 배우는곳에서 지도를 받아야 할수 있다고 생각하시는게 대부분인데요,
나뭇잎이나,꽃 정도는 방법만,순서만 안다면 초보자도 처음하는 분들이라도
금방 따라하실수 있습니다.

준비한 MDF화병 반제에 검정색과 물을 2:1 비율로 섞어 바탕색을 칠합니다.

한쪽 방향으로 칠하며,완전히 마르면 다시 한번 칠해줍니다.

사진과 같이 테두리 부분에 금색을 칠합니다. 검정색에 흐르지 않도록 주의해서 칠하세요.
(원하는 다른 색상을 칠해도 좋습니다.)

스텐실을 할 바탕이 검정색일 경우 색상이 잘 나올수 있도록 먼저 흰색으로 찍는 납작한 스텐실 붓에 흰색을 묻힌
후 키친타월이나 헝겊에 농도 조절후 톡톡톡 두드립니다. (헝겊에 톡톡 두드리는게 스텐실의 농도를 일정하게 유지 하기 위해서는 매우 중요한 순서 입니다.

준비한 스텐실 본을 화병에 고정후(고정시에는 마스킹 테이프를 이용하세요.) 위에서 아래로 톡톡~ 두드립니다.
스텐실 붓에는 물을 묻히지 않고 물감을 붓 끝에만 살짝 묻혀서 찍으시면 됩니다. 계속 톡톡톡 두드립니다.
천천히 붓사이에 있던 물감들이 뿌린듯한 느낌으로 묻어 납니다.
본이 한장일 경우 예로..나무의 꽃부분이나, 열매 부분이 서로 다른색이 칠해져야 한다면.
마스킹 테이프로 필요없는 부분을 붙여 놓고 톡톡 찍어 주는 작업을 해줍니다.

옅은 노란색부터 톡톡 두들겨 주고,다음엔 그린색을 노란색 위에 두드립니다.
핑크색으로 영어의 아래부분이 진하게 살짝 찍어줍니다.키친타월이나 헝겊에 농도 조절하면서 잘 찍어주세요.
(색상의 순서는 옅은색상부터. 짙은 색상으로 작업을 합니다. 만일 짙은 색상위에 옅은 색상을 작업 해야 한다면.
백색을 한번 칠하고. 그위에 작업을 해주는게 더 효과 적입니다. 잘못하면, 바탕의 검은색이 베어 나올수가 있으니까요.)

마스킹 테이프를 반대 줄기 쪽에 붙혀놓고 열매에 스텐실을 합니다.
열매도 가장자리부터 안쪽으로 들어오면서 톡톡~~ 자! 완성이 됐으면 본을 띠어주세요.

나뭇잎의 표현을 가는 라이너 붓으로 그린색을 묻혀 그려줍니다. 열매에는 흰색으로 포인트를 주고,나뭇잎도 흰색으로 살짝..^^







